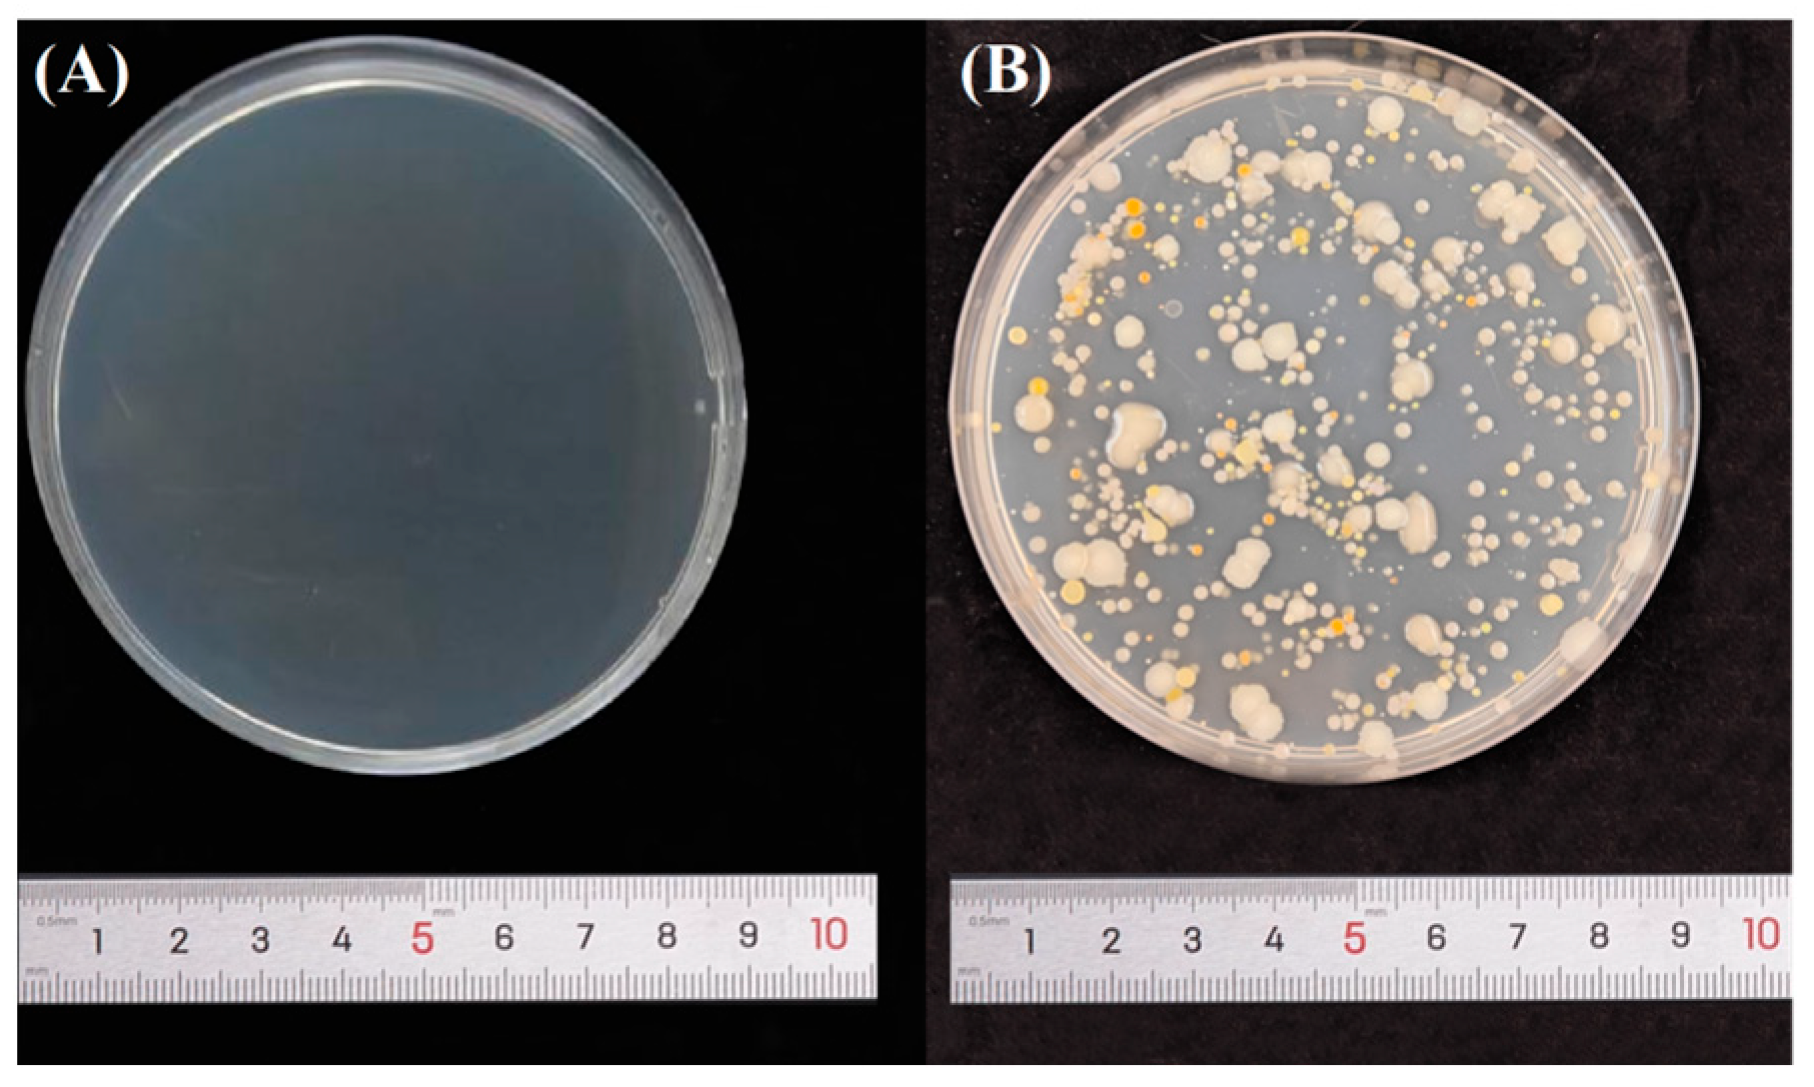
Coatings 14 01430 g013

Reinforcement of Oracle Bones Using a Novel Silicone Coupling Reagent for Preservation
Abstract
1. Introduction
2. Materials and Methods
2.1. Reagents and Materials
2.2. Bovine Bone Samples
- The bones were boiled for 1 h in a solution of sodium bicarbonate to remove oil and grease;
- The cooled bones were dried in the air for 2 d and then sawed into rectangles of similar size by using a Low Speed Diamond Saw (SYJ-150, Shanghai Optical Instrument Factory, Shanghai, China);
- The cut bones were placed in a muffin pan, burned at 550 °C for 4 h and then cooled for 8 h;
- The resulting bones were soaked in 4.5% hydrochloric acid for 5 min, rinsed with water three to four times, and then dried in the air for 2 d.
2.3. Simulated Bone Samples
2.4. Plate-Coated Colony Counting Assay
- 500 g of soil was collected, soaked in deionized water, covered with the soil surface for 2–5 cm, stirred and settled overnight, and an appropriate amount of supernatant was taken as the source of the flora for this characterization experiment.
- Sample A, treated by DESPMA, had a solution of soil dropped onto on the surface. As the liquid needs to wrap around the sample surface as much as possible, the liquid was spread as far as possible.
- The sample B, without the DESPMA, had a solution of soil dropped onto the surface. As the liquid needs to wrap around the sample surface as much as possible, the liquid was spread as far as possible.
- The incubation temperature was 37 °C, the humidity was 60%–98%, and the incubation time was 24/48/72 h.
- After incubation, 10 (L medium) was taken from the surface of samples A and B. The solutions were coated in three gradients and counted separately, namely, 1×, 10× and 100×.
3. Results
3.1. Micro-Structure Evolution of the Simulated Bone Samples
3.2. Surface Hardness Change
3.3. Consolidation of Reagents
3.4. Volatility of Reagents
3.5. Reagent Protection
3.6. Effects of Bacteria on Agar Plates
3.7. Effects of Bacteria on the Bone Samples
4. Conclusions
Author Contributions
Funding
Institutional Review Board Statement
Informed Consent Statement
Data Availability Statement
Conflicts of Interest
References
- Wang, C.; Yang, Q.; Liu, L.; Yang, J.; Zhou, W.; Dang, X. Status of research on the conservation of bone and antler relics. Sci. Conserv. Archaeol. 2016, 1, 118–125. [Google Scholar]
- Du, A.; Ma, Y. Conservation treatment of Yinxu oracle bone inscriptions. Cult. Relics Cent. China 2007, 6, 87–90. [Google Scholar]
- Flad, R.K. Divination and power: A multiregional view of the development of oracle bone divination in early China. Curr. Anthropol. 2008, 49, 403–437. [Google Scholar] [CrossRef]
- Qiao, R.; Yang, L.; Pang, K. Making visual sense of oracle bones for you and me. In Proceedings of the IEEE/CVF Conference on Computer Vision and Pattern Recognition (CVPR), Seattle, WA, USA, 17–21 June 2024; pp. 12656–12665. [Google Scholar]
- Wang, C.; Bai, C.; Yang, J.; Wang, Y. Study on the conservation status of Zhouyuan oracle bones. Sci. Conserv. Archaeol. 2015, 1, 003. [Google Scholar]
- Lemaire, A.; Varin, J.; Lamret, F. Staphylococcus aureus behavior on artificial surfaces mimicking bone environment. Pathogens 2023, 12, 384. [Google Scholar] [CrossRef]
- Wu, Y.; Lan, J.; Wu, M. Processing, microstructure, and performance of robocast clay-based ceramics incorporating hollow alumina microspheres. Materials 2024, 17, 1603. [Google Scholar] [CrossRef]
- Chen, X.; Yuan, S. Conservation of Zhouyuan oracle bone inscriptions. J. Natl. Mus. China 2002, 000, 81–87. [Google Scholar]
- Pérez, L.; Sanchis, A.; Hernández, C.M.; Galván, B.; Sala, R.; Mallol, C. Hearths and bones: An experimental study to explore temporality in archaeological contexts based on taphonomical changes in burnt bones. J. Archaeol. Sci. Rep. 2017, 11, 287–309. [Google Scholar] [CrossRef]
- Ullmann, P.V.; Schweitzer, M.H. A statistical meta-analysis of lithologic and other potential controls on fossil bone cellular and soft tissue preservation. Palaios 2023, 38, 246–257. [Google Scholar] [CrossRef]
- Kibblewhite, M.; Tóth, G.; Hermann, T. Predicting the preservation of cultural artefacts and buried materials in soil. Stoten 2015, 529, 249–263. [Google Scholar] [CrossRef]
- Yuan, S.; Wu, X.; Liu, K.; Guo, Z.; Cheng, X.; Pan, Y.; Wang, J. Removal of contaminants from oracle bones during sample pretreatment. Radiocarbon 2007, 49, 211–216. [Google Scholar] [CrossRef]
- Liu, Y.; Lu, R.; He, L.; Wang, X.; Wang, L.; Lv, X.; Zhang, K.; Yang, F. Consolidation of fragile oracle bones using nano calcium sulfate hemihydrate as a protectant. Coatings 2022, 12, 860–871. [Google Scholar] [CrossRef]
- Zhao, X.; Tang, J.; Gu, Z.; Shi, J.; Yang, Y.; Wang, C.J. Investigating the tool marks on oracle bones inscriptions from the Yinxu site, Henan province, China. Microsc. Res. Tech. 2016, 79, 827–832. [Google Scholar] [CrossRef]
- Richter, A. Stories of coping with sickness: Illness narratives in early medieval Chinese anecdotal literature. Chin. Med. Cult. 2023, 6, 175–182. [Google Scholar] [CrossRef]
- Liang, L.; Li, L. On diet and disease in oracle bone inscriptions. Chin. Med. J. 2023, 44, 77–80. [Google Scholar]
- Hyeok, K. A study on the relationship between the period of oracle bone inscriptions and the development of character forms. J. Chin. Writ. Syst. 2023, 7, 86–89. [Google Scholar]
- Xiao, L.; Sun, J. Study on temporary protection of ivories, buckteeth and antlers unearthed from Jinsha site. Sci. Conserv. Archaeol. 2002, 14, 26–30. [Google Scholar]
- Liu, Z. Preservation and scientific analysis of oracle objects: A preliminary study of oracle maintenance methods in the institute of history and language. J. Cult. Herit. Conserv. 2022, 61, 7–38. [Google Scholar]
- North, A.; Balonis, M.; Kakoulli, I. Biomimetic hydroxyapatite as a new consolidating agent for archaeological bone. Stud. Conserv. 2016, 61, 146–161. [Google Scholar] [CrossRef]
- Smith, D.R.; Martin, E.K.; Kaufman, B.L. The bottom line: Exploring analytical methods for assessing preservation in archaeological bone using ftir-atr. J. Archaeol. Sci. Rep. 2023, 50, 104014. [Google Scholar] [CrossRef]
- Yang, L.; Zhang, J.; Huang, J. Cause analysis and application of surface deepening effect of paraloid b72 reinforcement agent for cultural relics. West. Archaeol. 2021, 1, 315–321. [Google Scholar]
- Zheng, J. Application of acrylic resin in the field of cultural relics protection. World Antiq. 2018, 06, 74–76. [Google Scholar]
- Li, Y.; Ling, X.; Yang, L.; Zhao, X.; Sun, M. Application of modern chemical materials in the protection of bone and keratin relics. Polym. Mater. Sci. Eng. 2021, 37, 8. [Google Scholar]
- Du, A.; Zhou, S. Scientific analysis and restoration of several bronze artifacts. Cult. Relics Prot. Archaeol. Sci. 2004, 46–51. [Google Scholar]
- Wang, J. Application of organosilicon materials in the protection of stone cultural relics against weathering. J. Longdong Univ. Nat. Sci. Ed. 2020, 31, 5. [Google Scholar]
- Wang, W.; Fan, M.; You, S. Study on the reinforcement of ancient brick wall cultural relics by silicone composite materials. Guangdong Chem. Ind. 2013, 44–45. [Google Scholar]
- Zhao, P.; Zhang, Y.S.; Shen, Y. Advancements in artificial hydraulic lime composites for sustainable restoration of stone cultural heritage. Sci. Adv. Mater. 2023, 12, 15. [Google Scholar] [CrossRef]
- Xu, J.; Zhang, T.; Jiang, Y. Nano-silica/fluorinated polyacrylate composites as surface protective coatings for simulated stone cultural relic protection. J. Appl. Polym. Sci. 2022, 139, 52953. [Google Scholar] [CrossRef]
- Moszner, N.; Hirt, T. New polymer-chemical developments in clinical dental polymer materials: Enamel–dentin adhesives and restorative composites. J. Polym. Sci. Part A Polym. Chem. 2012, 50, 4369–4402. [Google Scholar] [CrossRef]
- Pimentel, R.; Paula, L.; Ribeiro, E. Evaluation of the bond strength of self-etching adhesive systems containing HEMA and 10-MDP monomers: Bond strength of adhesives containing HEMA and 10-MDP. Int. J. Dent. 2022, 1, 5756649. [Google Scholar]
- Zhang, X.; Liu, F.; Li, X. The fabrication of hybrid micelles with enhanced permeability for drug delivery via a diethoxymethylsilyl-based crosslinking strategy. J. Polym. Chem. 2019, 10, 4529–4536. [Google Scholar] [CrossRef]
- Zhang, X.; Wang, P.; Wang, X. Stabilized, ROS-sensitive β-cyclodextrin-grafted hyaluronic supramolecular nanocontainers for CD44-targeted anticancer drug delivery. Colloids Surf. B Biointerfaces 2024, 242, 114081. [Google Scholar] [CrossRef] [PubMed]
- Barrett, T.H. Japanese monks and chinese books: Glimpses of buddhist sinology in early tokugawa japan. Religions 2021, 12, 871. [Google Scholar] [CrossRef]
- Chen, X.; Yuan, S. Study on the burning condition and weathering causes of zhouyuan oracle bones. Sci. Conserv. Archaeol. 2004, 16, 20–28. [Google Scholar]
- Liu, Y.; Zhang, Y.; Wang, Q.; Li, T.; Ma, W.; Yang, F.; Chen, L.; Zhao, D.; Yan, X. Consolidation of fragile weathered bone relics using hydroxyapatite material as consolidant. J. Inorg. Mater. 2023, 38, 1345–1354. [Google Scholar] [CrossRef]
- Yilgör, E.; Yilgör, I. Silicone containing copolymers: Synthesis, properties and applications. Prog. Polym. Sci. 2014, 39, 1165–1195. [Google Scholar] [CrossRef]

| Water | Organic Matter | Carbonate | Soils | Hydroxyapatite |
|---|---|---|---|---|
| 2.40 | 8.24 | 3.13 | 13.56 | 72.68 |
| Solution | Day 1 | Day 7 | Day 14 | Day 21 | Day 28 |
|---|---|---|---|---|---|
| DESPMA | 0 | 0 | 0 | 2 | 4 |
| PS | 0 | 0 | 2 | 5 | 6 |
| B72 | 0 | 0 | 2 | 4 | 5 |
| Water | 0 | 0 | 3 | 5 | 8 |
| Solution | Day 1 | Day 7 | Day 14 | Day 21 | Day 28 |
|---|---|---|---|---|---|
| DESPMA | 0 | 0 | 2 | 3 | 5 |
| PS | 0 | 3 | 5 | 7 | 8 |
| B72 | 0 | 2 | 4 | 6 | 8 |
| Water | 0 | 3 | 3 | 7 | 9 |
Disclaimer/Publisher’s Note: The statements, opinions and data contained in all publications are solely those of the individual author(s) and contributor(s) and not of MDPI and/or the editor(s). MDPI and/or the editor(s) disclaim responsibility for any injury to people or property resulting from any ideas, methods, instructions or products referred to in the content. |
© 2024 by the authors. Licensee MDPI, Basel, Switzerland. This article is an open access article distributed under the terms and conditions of the Creative Commons Attribution (CC BY) license (https://creativecommons.org/licenses/by/4.0/).
Share and Cite
Gao, F.; Liu, Q.; Wang, P.; Liu, Y. Reinforcement of Oracle Bones Using a Novel Silicone Coupling Reagent for Preservation. Coatings 2024, 14, 1430. https://doi.org/10.3390/coatings14111430
Gao F, Liu Q, Wang P, Liu Y. Reinforcement of Oracle Bones Using a Novel Silicone Coupling Reagent for Preservation. Coatings. 2024; 14(11):1430. https://doi.org/10.3390/coatings14111430
Chicago/Turabian StyleGao, Feng, Qiyu Liu, Peipei Wang, and Yongge Liu. 2024. "Reinforcement of Oracle Bones Using a Novel Silicone Coupling Reagent for Preservation" Coatings 14, no. 11: 1430. https://doi.org/10.3390/coatings14111430
APA StyleGao, F., Liu, Q., Wang, P., & Liu, Y. (2024). Reinforcement of Oracle Bones Using a Novel Silicone Coupling Reagent for Preservation. Coatings, 14(11), 1430. https://doi.org/10.3390/coatings14111430





